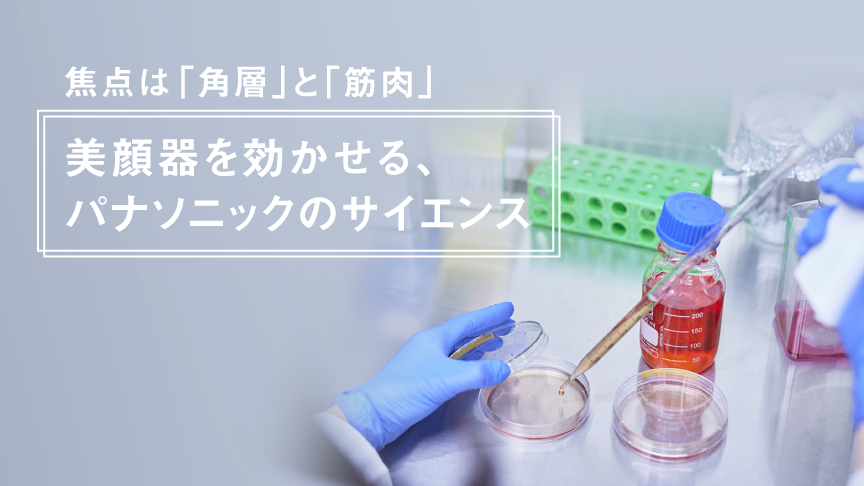
焦点は「角層」と「筋肉」 美顔器を効かせる、パナソニックのサイエンス

ビューティ カテゴリー概要 (美容家電総合)
髪型がきまる、肌の調子がいい、
そんな、ちょっとした変化で心が躍る。
年齢や性別にとらわれず、
心地よい自分を探そうとする
すべての人のために。
一人ひとりが願う美しさを
テクノロジーと科学のチカラで
磨き、育む。
あなたの毎日が美しく輝きますように。
リフトケア※1を選んだあなたにおすすめ
※1 引き上げるように機器を動かすこと
※2 年齢に応じた、13役以上の機器を使った肌ケアのこと
※3 電気刺激を筋肉に伝え、筋肉を収縮させること
新商品・注目商品
新作や注目度の高い売れ筋商品をご紹介します
お役立ちコンテンツ
※ 不調とは、生理周期や睡眠状態に関係した体調変化のこと
掲載商品の価格には、配送・設置調整費、工事費、使用済み商品の引き取り費等は含まれておりません。